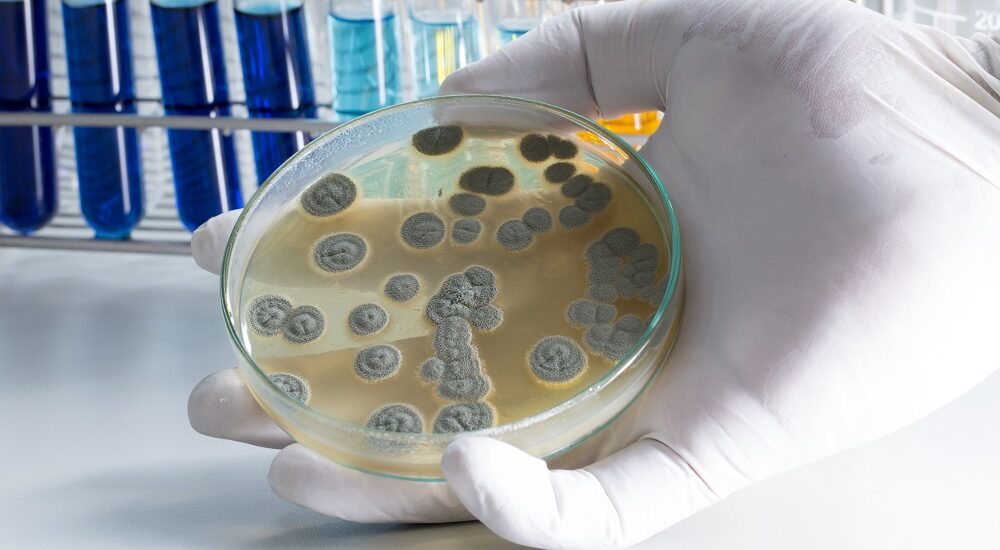

The Global Microbial Therapeutic Products Industry is on the verge of significant expansion, according to a new report released by Future Market Insights (FMI). The study forecasts a robust Compound Annual Growth Rate (CAGR) of 7.5% between 2022 and 2030, positioning the industry for remarkable growth over the next decade.
In 2022, the market is valued at US$ 17.11 billion, and FMI’s projections suggest a compelling surge, anticipating a leap to over US$ 30.55 billion by the end of 2030. This growth trajectory is attributed to key drivers, notably the escalating prevalence of antimicrobial resistance and the rising demand for innovative biotherapeutics.
Microbial therapeutic products, as outlined in the report, encompass a diverse range of biotherapeutics derived from microorganisms, including bacteria, fungi, and algae. This category includes recombinant therapeutic proteins, live biotherapeutics, microbial vaccines, nucleic acid therapy, phage therapy, and microbial metabolites.
Over the years, the burden of antimicrobial resistance (AMR) has been escalating tremendously, besides the prevalence of chronic conditions. The World Health Organization observes high resistance rates have been observed against antimicrobials used for treating urinary tract infections and certain types of diarrhea. For example, the rate of resistance to ciprofloxacin ranged anywhere between 8.4% and 93% across 33 countries. It is apprehended that this burden is compounding further due to the COVID-19 pandemic. Hence, efforts are underway to accelerate research for discovering breakthroughs in microbial therapeutics.
Request a Sample of this Report Now!
https://www.futuremarketinsights.com/reports/sample/rep-gb-12891
Global Microbial Therapeutic Products Industry Key Takeaways
- By product, anti-cancer agents to capture nearly 30% revenue by 2020-end, owing to prolific research breakthroughs
- By route of administration, injection pens to account for 2 out of 5 sales, attributed to patient hygiene concerns
- By source, bacteria based microbial therapeutic products to remain preferred
- Oncology to remain primary microbial therapeutic products application area, expanding at Y-o-Y rate exceeding 5% through 2020
- Hospitals emerge as the primary microbial therapeutic end-users, attributed to availability of adequate infrastructure
- North America to remain the market hegemon, East Asia to be fastest growing market
“Prominent manufacturers are seeking regulatory approvals to accelerate research and development operations for developing effective drug solutions to address the compounding antimicrobial resistance problems,” remarks Sabyasachi Ghosh (Associate Vice President at Future Market Insights, Inc.)
Global Microbial Therapeutic Products Industry Competitive Landscape:
Prominent players operating in the Global Microbial Therapeutic Products Industry are emphasizing on acquiring regulatory approvals, forging partnerships and collaborations with competent authorities and biosimilars develop to capture substantial revenue shares across key regions.
Some reputed players operating within the global microbial therapeutic products landscape include Dr. Reddy’s Laboratories, Pfizer Inc., Sanofi SA, Merck & Co. Inc., Novartis AG, Novo Nordisk A/S, Abbott Laboratories and Amgen Inc. to name a few.
Examining the underlying assumptions of the study. Ask An Analyst
https://www.futuremarketinsights.com/ask-the-analyst/rep-gb-12891
In November 2020, Dr. Reddy’s Laboratories announced a definitive agreement with Glenmark Pharmaceuticals Ltd. to acquire its anti-allergy brands Momat Rino, Momat Rino Advance and Momat A to market them across Russia, Kazakhstan and Uzbekistan respectively.
In December 2020, Novo Nordisk announced the acquisition of Emisphere Technologies to exercise ownership of its Eligen SNAC oral delivery technology. The acquisition shall accelerate its GLP-1 receptor agonist seaglutide’s production on a larger scale.
Key Segments of Global Microbial Therapeutic Products Industry Survey
Global Microbial Therapeutic Products Industry by Product:
- Growth Factors
- GCSF
- Peg GCSF
- Exenatide
- Anti-cancer Agents
- Immunosuppressants
- Enzymes
- Others
Global Microbial Therapeutic Products Industry by Route of Administration:
- Single-use Pre-filled Injection/Injector Pens
- Multi-use Injectors
- Others
Global Microbial Therapeutic Products Industry by Source:
- Bacteria
- Fungi
Global Microbial Therapeutic Products Industry by Application:
- Metabolic Disorders
- Hematological Disorders
- Oncology
- Immunological Disorders
- Infectious Diseases
- Allergic Diseases
- Others
Global Microbial Therapeutic Products Industry by End User:
- Hospitals
- Pharmaceuticals & Biopharmaceutical Companies
- Research & Academic Institutions
Get Your Customized Impactful Report Now!
https://www.futuremarketinsights.com/customization-available/rep-gb-12891
Author
Sabyasachi Ghosh (Associate Vice President at Future Market Insights, Inc.) holds over 12 years of experience in the Healthcare, Medical Devices, and Pharmaceutical industries. His curious and analytical nature helped him shape his career as a researcher.
Identifying key challenges clients face and devising robust, hypothesis-based solutions to empower them with strategic decision-making capabilities come naturally to him. His primary expertise lies in areas such as Market Entry and Expansion Strategy, Feasibility Studies, Competitive Intelligence, and Strategic Transformation.
Holding a degree in Microbiology, Sabyasachi has authored numerous publications and has been cited in journals, including The Journal of mHealth, ITN Online, and Spinal Surgery News.
About Future Market Insights (FMI)
Future Market Insights, Inc. (ESOMAR certified, recipient of the Stevie Award, and a member of the Greater New York Chamber of Commerce) offers profound insights into the driving factors that are boosting demand in the market. FMI stands as the leading global provider of market intelligence, advisory services, consulting, and events for the Packaging, Food and Beverage, Consumer Technology, Healthcare, Industrial, and Chemicals markets. With a vast team of over 5,000 analysts worldwide, FMI provides global, regional, and local expertise on diverse domains and industry trends across more than 110 countries.
Contact Us:
Future Market Insights Inc.
Christiana Corporate, 200 Continental Drive,
Suite 401, Newark, Delaware – 19713, USA
T: +1-845-579-5705
For Sales Enquiries: sales@futuremarketinsights.com
Website: https://www.futuremarketinsights.com
LinkedIn| Twitter| Blogs | YouTube